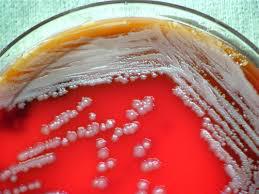

Press release
EMEA Sterility Testing Market 2023 Top Key Players are Merck KGaA, bioMérieux SA, SGS SA, Sartorius AG, Thermo Fisher Scientific Inc. , Toxikon, Inc., Charles River, and others
Market Research Future has recently added another market study to its extensive research portfolio, titled “EMEA Sterility Testing Market Size, Status and Forecast 2023”. The report offers intelligent insights and uses thorough examination of market factors to gauge market size and development.The EMEA Sterility Testing Market is expected to grow at an approximate CAGR of 10.8% during the forecast period.
Key players for EMEA Sterility Testing Market
Merck KGaA (Germany), bioMérieux SA (France), SGS SA (Switzerland), Sartorius AG (Germany), Thermo Fisher Scientific Inc. (U.S.), Toxikon, Inc. (U.S.), Charles River (U.S.), and others.
Get Premium Sample Copy @ https://www.marketresearchfuture.com/sample_request/596
Market Scenario:
Sterilisation is any process that effectively eradicates any surface, equipment or article from the presence of viable microorganisms. Sterility testing is one of the important aspects of the healthcare sector which ensures the purity and safety of a product or a substance. Increasing prevalence of chronic diseases like cancer and HIV which can be easily transferred from the patient to the healthy adults through the use of the contaminated articles is one of the major drivers for the market growth. In 2015, according to the Centers for Disease Control and Prevention, 9,250 out of every 10,000 exposures to infected blood transfusion resulted in the transmission of the HIV. Similar, results were estimated by the use of infected needle during the parenteral intake of the drugs, 63 out of every 10,000 such exposures led to HIV. Moreover, expanding pharmaceutical and biotech industries, the rise in the approval of the drugs, growth in R&D investments in life science research along with rising healthcare and government support is expected to boost the market growth during the forecast period. However, precise regulatory and time-consuming approval processes along with the lack of skilled labor will restrain the market growth during the forecast period.
Segmentation:
The EMEA Sterility Testing Market is segmented on the basis of product, test, application and end users.
On the basis of the product, the market is segmented into kits & reagents, services, instruments, and others.
On the basis of the test, the market is segmented into membrane filtration, direct inoculation sterility testing, and others. The membrane filtration segment is sub-segmented into membrane type which is further segmented into synthetic organic polymers and inorganic materials. The synthetic organic polymers, by membrane type, is sub-segmented into polysulfone, cellulose acetate, and others. The inorganic materials, by membrane type, is sub-segmented into ceramic membranes, metal membranes, others.
On the basis of the application, the market is segmented into pharmaceutical industries, biotechnology industries, and others.
On the basis of the end users, the market is segmented into hospitals & clinics, academic institutes, research organization, and others.
Apply for Valuable Discount @ https://www.marketresearchfuture.com/check-discount/596
Regional Analysis:
Europe is the largest sterility testing market. High healthcare expenditures, government support for research & development and huge patient population drives the European market. Moreover, growing biotechnology and pharmaceutical industries is boosting the market growth. Additionally, the presence of the developed economies within the region like the U.K and France is fuelling the market growth during the forecast period. Regionally Europe is divided into Western Europe and Eastern Europe. Western Europe leads the market within the region. On the other hand, there are huge opportunities for the market growth in Eastern Europe.
Asia Pacific is the fastest growing region in EMEA market due to the presence of a huge patient population and continuously developing economies like India and China which have a growing healthcare industry. According to the Indian Brand Equity Foundation, in 2017, the Indian healthcare sector is one of the fastest growing industries and is expected to advance at a CAGR of 22.8% and reach USD 280 billion by 2020. Additionally, favorable government policies like reduced excise and customs duty followed by the exemptions in service tax in India boosts the regional market growth.
The Middle East & Africa holds the least share in the EMEA sterility testing market due to the presence of poor economies in the African region owing to the low per capita income and stringent government policies within the region. A majority of the Middle East & Africa market is held by the Middle East due to huge healthcare expenditures and presence of developed economies like Kuwait, Saudi Arabia, Dubai, and Qatar.
TABLE OF CONTENT
Chapter 1. Report Prologue
Chapter 2. Market Introduction
2.1 Definition
2.2 Scope of the Study
2.2.1 Research Objective
2.2.2 Assumptions
2.2.3 Limitations
Chapter 3. Research Methodology
3.1 Introduction
3.2 Primary Research
3.3 Secondary Research
3.4 Market Size Estimation
Chapter 4. Market Dynamics
4.1 Drivers
4.2 Restrains
4.3 Opportunities
4.4 Challenges
4.5 Macroeconomic Indicators
4.6 Test Trends & Assessment
…Continued
Reports Enquiry @ https://www.marketresearchfuture.com/enquiry/596
Market Research Future (MRFR), enable customers to unravel the complexity of various industries through Cooked Research Report (CRR), Half-Cooked Research Reports (HCRR), Raw Research Reports (3R), Continuous-Feed Research (CFR), and Market Research & Consulting Services.
Market Research Future
Office No. 528, Amanora Chambers
Magarpatta Road, Hadapsar,
Pune - 411028
Maharashtra, India
Phone: +1 646 845 9312
Email: sales@marketresearchfuture.com
This release was published on openPR.
Permanent link to this press release:
Copy
Please set a link in the press area of your homepage to this press release on openPR. openPR disclaims liability for any content contained in this release.
You can edit or delete your press release EMEA Sterility Testing Market 2023 Top Key Players are Merck KGaA, bioMérieux SA, SGS SA, Sartorius AG, Thermo Fisher Scientific Inc. , Toxikon, Inc., Charles River, and others here
News-ID: 1162202 • Views: …
More Releases from Market Research Future
Conversational Artificial Intelligence Market to Reach USD 35.0 Billion by 2035, …
Conversational Artificial Intelligence Market Overview:
The Conversational Artificial Intelligence (AI) Market is witnessing remarkable expansion as enterprises increasingly deploy AI-driven communication technologies to enhance customer engagement and operational efficiency. According to Market Research Future (MRFR), the global Conversational AI Market is projected to grow from USD 9.81 Billion in 2024 to USD 35.0 Billion by 2035, demonstrating a strong growth trajectory across industries.
Conversational AI solutions-powered by Natural Language Processing (NLP), machine…
Glue Machine Market to Reach USD 14.9 Billion by 2035, Growing at 4.56% CAGR
The Glue Machine Market is witnessing significant growth due to the increasing adoption of adhesive technologies across various industries, including packaging, woodworking, automotive, furniture, and construction. Valued at USD 9.15 billion in 2024, the market is projected to reach USD 14.9 billion by 2035, registering a CAGR of 4.56% between 2025 and 2035.
Glue machines, also known as adhesive application machines, are critical for efficiently dispensing adhesives in industrial and commercial…
Expansion Valves Market to Reach USD 5.39 Billion by 2035, Growing at 4.62% CAGR
The expansion valves market is witnessing steady growth due to increasing demand for efficient heating, ventilation, air conditioning, and refrigeration (HVACR) systems across residential, commercial, and industrial sectors. Valued at USD 3.28 billion in 2024, the market is projected to reach USD 5.39 billion by 2035, growing at a CAGR of 4.62% between 2025 and 2035.
Expansion valves, also known as thermostatic expansion valves (TXVs) or electronic expansion valves (EEVs), are…
Cheese Packaging Market to Reach USD 101.31 Billion by 2034, Growing at 3.50% CA …
The Cheese Packaging Market is poised for steady growth over the next decade due to rising demand for dairy products, evolving consumer preferences, and increasing focus on food safety and sustainability. According to recent estimates, the market was valued at USD 71.87 billion in 2024 and is projected to reach USD 101.31 billion by 2034, growing at a compound annual growth rate (CAGR) of 3.50% between 2025 and 2034.
Cheese packaging…
More Releases for EMEA
Fragrant Solutions: EMEA Dearomatic Solvents Market
Persistence Market Research delivers key insights on the EMEA de-aromatic solvents market in its latest report titled, "EMEA Dearomatic Solvents Market: High Flash Point Grade Segment to Witness Relatively Faster Growth Between 2016 and 2024 ." The EMEA de-aromatic solvents market is projected to register a CAGR of 5.0% over the forecast period (2016 - 2024) and North Africa and Spain are expected to witness the highest growth in the…
EMEA (EMEA, Middle East and Africa) Aircraft Avionic Systems Market Report 2018
Report has added a new report to its source. The report is titled “EMEA Aircraft Avionic Systems Market Research Report 2018” and accelerates a wide-ranging and focused look into this market. Market size is concluded through detailed study and examination through subordinate research.
The current generation aircraft utilize the fly-by-wire (FBW) control systems which have helped significantly reduce the weight of aircraft and its maintenance costs. Flight management system (FMS)…
EMEA Automotive Robotics Comparative Market Analysis Report
EMEA Automotive Robotics Market Research Report provides insights of the industry over past 5 years and a forecast until 2022. The Report studies, the Market status and future trend in the EMEA market, splits by type and by applications, to fully and deeply researched and reveal the market situation and future forecast.
The Automotive Robotics Market report would come in handy to understand your competitors and give you an insight about…
Centrify appoints new EMEA Channel Director
Plans to select top tier partners in each region and introduce boot-camp style training
Centrify, the leader in securing hybrid enterprises through the power of identity services, has appointed John Andrews as its new EMEA Channel Director. John, who reports to Vice President and Managing Director for EMEA, Andy Heather, will be responsible for setting out and delivering on the company’s long-term channel strategy and building a core set of distribution…
EMEA Meeting in Duesseldorf 2012
On November 2nd and 3rd, 2012, the international recruitment company AIMS International, which ranks among the top 10 Executive Search companies globally, celebrated its 20th anniversary at the Hyatt Regency Hotel in Düsseldorf in the media harbor. In Germany, the Executive Search industry is better known – or prejudiced – under the title headhunting. Why? The best management employees of competitor companies are identified on behalf of the clients by…
SeeTec increases market penetration in EMEA
Philippsburg, January 30th 2009: Within the growing market for video surveillance, network based solutions have achieved an important position – and their significance is set to grow. With a volume of nearly 500 million Euros, the IP video market is larger than ever before and experts are forecasting continuous high growth. According to the results of the recent IMS report from November 2008, SeeTec has been successful in achieving…